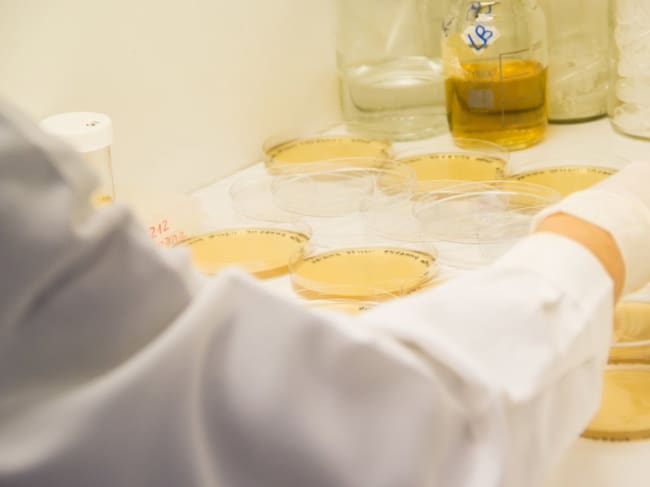
Placas de Petri/Archivo

Demuestran que las relaciones entre bacterias del suelo potencian el crecimiento de los cultivos
Los resultados muestran que los efectos beneficiosos de los microorganismos no dependen únicamente de cada bacteria por separado, sino de cómo se relacionan con otras especies del mismo entorno
Placas de Petri/Archivo / Junta de Andalucía

Un equipo de investigación de la Estación Experimental del Zaidín (EEZ-CSIC) en Granada y del Instituto Superior de Investigaciones Biológicas (Insibio, Conicet-UNT) en Argentina ha demostrado que las relaciones entre bacterias del suelo influyen en los beneficios que aportan a los cultivos.
En concreto, observaron que cuando dos bacterias mantienen una interacción positiva pueden potenciar funciones clave para la caña de azúcar, como mejorar la absorción de nutrientes, estimular el crecimiento de las raíces o reforzar su salud frente a patógenos.
Los resultados muestran que los efectos beneficiosos de estos microorganismos no dependen únicamente de cada bacteria por separado, sino de cómo se relacionan con otras especies del mismo entorno.
Las plantas albergan comunidades de bacterias que viven en su entorno inmediato o incluso dentro de sus tejidos. Algunas habitan en la capa de suelo que rodea las raíces, mientras que otras viven dentro de la propia planta sin causarle daño.
En este sentido, los investigadores observaron que las bacterias que viven alrededor de las raíces tienden a competir con mayor frecuencia, mientras que entre las que habitan el interior de los tejidos vegetales predominan las interacciones positivas.
La novedad que aporta este estudio es mostrar que las interacciones entre distintas bacterias pueden modificar procesos esenciales para la planta, como la absorción de nutrientes o la producción de compuestos que estimulan su crecimiento.
Aunque el trabajo no identifica todavía una combinación concreta de microorganismos lista para aplicar en campo, los investigadores destacan que comprender estas relaciones podría servir para desarrollar en el futuro 'cócteles' de microorganismos beneficiosos que mejoren el crecimiento de los cultivos y complementen el uso de fertilizantes tradicionales.
En la actualidad, muchos de estos productos se basan en una única bacteria.
Sin embargo, en la naturaleza las plantas conviven con consorcios complejos de microorganismos; es decir, comunidades de distintas bacterias que viven juntas e interactúan entre sí.
"Las funciones beneficiosas pueden depender de la interacción entre bacterias, por lo que analizar estos comportamientos es un paso fundamental para desarrollar consorcios microbianos que funcionen bien", señala a la Fundación Descubre el investigador de la EEZ-CSIC Manuel Espinosa.
COMPORTAMIENTO COLECTIVO
Según explica el equipo investigador en el artículo 'Interspecies interactions among sugarcane-associated bacteria and their impact on plant growth promotion traits', publicado en la revista Frontiers in Microbiology, muchas de las funciones atribuidas a bacterias beneficiosas surgen en realidad de su comportamiento colectivo dentro de la comunidad microbiana, es decir, a cómo se llevan entre ellas.
Para estudiar estas comunidades, los investigadores recogieron en campo plantas de caña de azúcar, un modelo ampliamente utilizado en microbiología agrícola por su importancia económica y por la cantidad de bacterias beneficiosas que alberga.
Luego, aislaron bacterias tanto de la superficie de las raíces como del interior de los tejidos. Después cultivaron los microorganismos in vitro en el laboratorio y analizaron su ADN para identificar las distintas especies presentes.
En total, aislaron 32 bacterias diferentes, 16 del entorno de las raíces y 16 del interior de los tejidos de la planta. A continuación, realizaron ensayos para comprobar cómo interactuaban entre sí.
Para ello, enfrentaron cada bacteria con las demás en 120 combinaciones posibles dentro de cada grupo, observando si su relación era positiva, negativa o neutra.
Los resultados mostraron que las bacterias de las raíces tendían a competir con mayor frecuencia, mientras que entre las del interior de los tejidos vegetales predominaban las interacciones positivas.
CAMBIOS DE FUNCIÓN
Además de estudiar cómo se relacionaban entre ellas, los científicos analizaron si estas interacciones modificaban funciones beneficiosas para las plantas.
Entre otras funciones, los investigadores analizaron si estas bacterias ayudan a la planta a alimentarse mejor y a crecer.
En concreto, comprobaron si son capaces de transformar nutrientes del suelo, como el fósforo --que suele estar presente en la tierra, pero no siempre en formas que la planta pueda absorber--, facilitar la captación de hierro o producir sustancias que estimulan el desarrollo de las raíces.
Los experimentos demostraron que estas funciones pueden aumentar, disminuir o cambiar dependiendo de qué otras bacterias estén presentes.
En algunos casos, una bacteria que no mostraba una función determinada cuando se cultivaba sola, pero podía activarla al interactuar con otra.
"Esto significa que el comportamiento beneficioso de estos microorganismos no puede predecirse únicamente estudiando cada especie por separado, sino que depende también de las relaciones que se establecen dentro de la comunidad microbiana", aclara Manuel Espinosa.
BIOFERTILIZANTES MÁS EFICACES
El siguiente paso del grupo Biología Integrativa de Bacterias Asociadas a Plantas de la EEZ-CSIC y del grupo Interacciones Microbianas del Instituto Superior de Investigaciones Biológicas será evaluar en experimentos con plantas en invernadero y posteriormente en campo si las combinaciones de bacterias que muestran interacciones positivas en el laboratorio pueden mejorar realmente el crecimiento y la salud de los cultivos a pie de campo.
De esta forma, esta estrategia podría contribuir a desarrollar estrategias agrícolas más sostenibles, que complementen el uso de fertilizantes tradicionales y mejoren la productividad en suelos pobres o degradados.
Este trabajo cuenta con financiación de la Consejería de Universidad, Investigación e Innovación de la Junta de Andalucía y de la Agencia Nacional de Promoción de la Investigación, el Desarrollo Tecnológico y la Innovación de Argentina.




